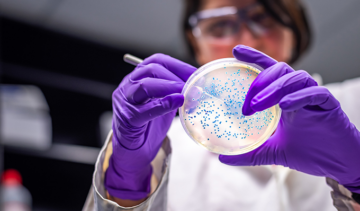

CNPQ E NEVS/FIOCRUZ BRASÍLIA
 O projeto é coordenado pela pesquisadora da Fiocruz Brasília Noely Moura, e conta com o financiamento do Departamento de Ciência e Tecnologia, da Secretaria de Ciência, Tecnologia, Inovação e Complexo da Saúde, do Ministério da Saúde (Decit/SECTICS/MS).
O projeto é coordenado pela pesquisadora da Fiocruz Brasília Noely Moura, e conta com o financiamento do Departamento de Ciência e Tecnologia, da Secretaria de Ciência, Tecnologia, Inovação e Complexo da Saúde, do Ministério da Saúde (Decit/SECTICS/MS).
✓ AVALIAÇÃO DO CENÁRIO DE RESISTÊNCIA ANTIMICROBIANA (RAM) EM HOSPITAIS UNIVERSITÁRIOS
O projeto “Avaliação do cenário de Resistência Antimicrobiana (RAM) em hospitais universitários e uma proposta de tecnologias para prevenção, controle e monitoramento das Infecções Relacionadas à Assistência à Saúde (Iras)”, é um projeto em rede entre a Fiocruz Brasília e a Universidade Federal de Pelotas, que foi contemplado na Chamada Programa Inova Fiocruz – Programa de Saúde em Pesquisa em Saúde Única – Edital FAPERGS/FIOCRUZ 13/2022 – Rede Saúde RS.O projeto é composto por três etapas:
O projeto “Avaliação do cenário de Resistência Antimicrobiana (RAM) em hospitais universitários e uma proposta de tecnologias para prevenção, controle e monitoramento das Infecções Relacionadas à Assistência à Saúde (Iras)”, é um projeto em rede entre a Fiocruz Brasília e a Universidade Federal de Pelotas, que foi contemplado na Chamada Programa Inova Fiocruz – Programa de Saúde em Pesquisa em Saúde Única – Edital FAPERGS/FIOCRUZ 13/2022 – Rede Saúde RS.O projeto é composto por três etapas:
1. Prospecção tecnológica e científica do uso de tecnologias em saúde em hospitais para o tratamento da Resistência Antimicrobiana (RAM);
2. Estudo retrospectivo dos casos de RAM em hospitais universitários, com ferramentas de análise de dados para identificação de tendências de uso de antimicrobianos e de infecções causadas por microrganismos resistentes no hospital, permitindo a identificação do cenário da RAM em hospitais universitários;
3. Implementação de estratégias para otimizar e aprimorar programas de gestão de RAM, com o amadurecimento de tecnologia de um biomaterial antimicrobiano à base de celulose bacteriana funcionalizada com pentóxido de nióbio e óxido de grafeno para aplicação frente a cepas multirresistentes que já vem sendo investigado pelo grupo de pesquisa do professor da UFPel Rafael Lund.
✓ CENÁRIO BRASILEIRO DE USO DE ANTIMICROBIANOS E O PERFIL DE RESISTÊNCIAIDENTIFICADO NO SUS, 2015 A 2019
 O projeto tem como finalidade analisar o cenário brasileiro do uso de antibióticos fornecidos pelo SUS, tomando como referência o perfil de resistências aos antimicrobianos, oferecendo informações aos gestores, profissionais da saúde e à sociedade brasileira. Visando beneficiar a comunidade como um todo, seja gestores, profissionais da saúde e a população em geral.
O projeto tem como finalidade analisar o cenário brasileiro do uso de antibióticos fornecidos pelo SUS, tomando como referência o perfil de resistências aos antimicrobianos, oferecendo informações aos gestores, profissionais da saúde e à sociedade brasileira. Visando beneficiar a comunidade como um todo, seja gestores, profissionais da saúde e a população em geral.
Com o advento da pandemia, a equipe de pesquisadores decidiu ampliar o período de análise, para verificar também o impacto da pandemia e dos tratamentos indicados na resistência aos antimicrobianos. Adicionalmente, foi sugerida a criação de um observatório nacional de resistência aos antimicrobianos, contendo os principais dados sobre o tema, bem como as publicações científicas e notas técnicas relacionadas.
O projeto encontra-se em andamento (agosto/2019 a fevereiro/2024).